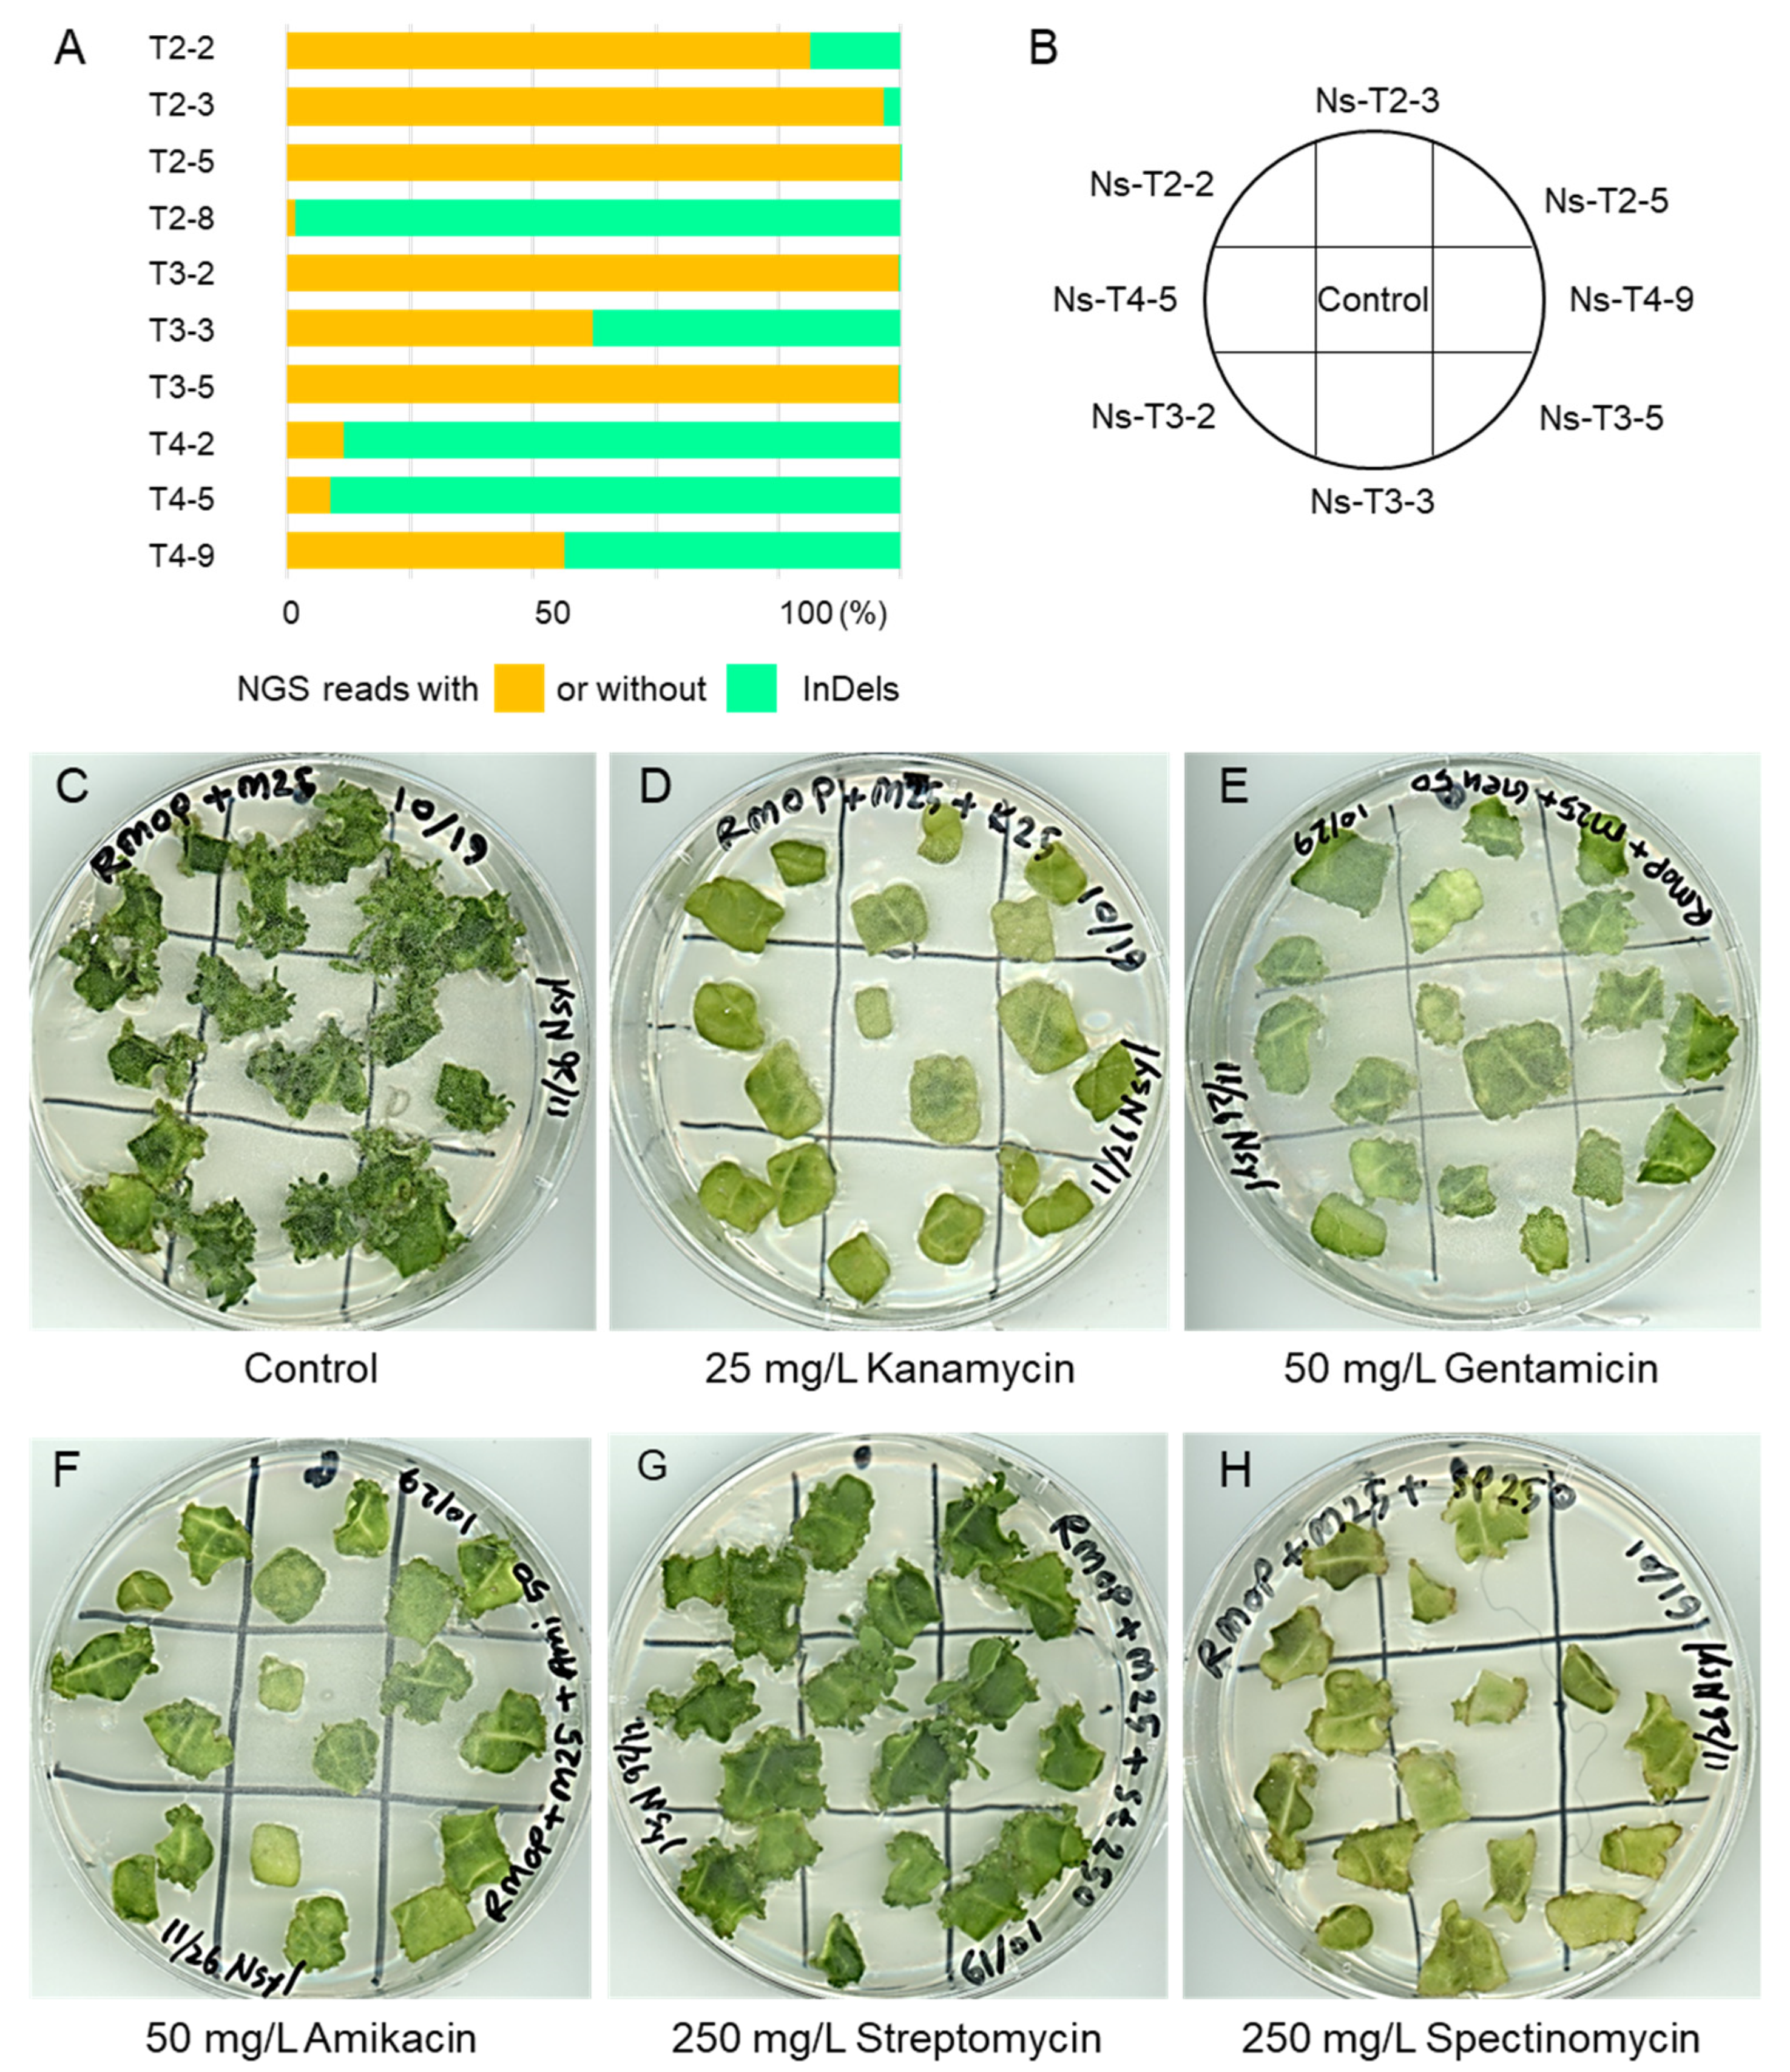
Ijms 23 02006 g004

Knockout of Tobacco Homologs of Arabidopsis Multi-Antibiotic Resistance 1 Gene Confers a Limited Resistance to Aminoglycoside Antibiotics
Abstract
1. Introduction
2. Results
2.1. Identification of Tobacco Homologs of Arabidopsis MAR1/RTS3
2.2. CRISPR/Cas9-Mediated Mutagenesis of MAR1/RTS3 Homologs in Tobacco Plants
2.3. Mutations of Tobacco MAR1/RTS3 Homologs Failed to Confer Aminoglycoside Resistance in Tissue Culture of the T0 Generation
2.4. Knockout of Tobacco MAR1/RTS3 Homologs Conferred a Limited Aminoglycoside Resistance in Seedlings
2.5. Knockout of Tobacco MAR1/RTS3 Homologs Failed to Confer Aminoglycoside Resistance in Tissue Culture
3. Discussion
4. Materials and Methods
4.1. Identification of Tobacco Homologs of Arabidopsis MAR1/RTS3
4.2. Vector Construction
4.3. Plant Transformation
4.4. Mutation Detection by Cleaved Amplified Polymorphic Sequences (CAPS) Analysis and Sequencing
4.5. Evaluation of Antibiotic Resistance
5. Conclusions
Supplementary Materials
Author Contributions
Funding
Institutional Review Board Statement
Informed Consent Statement
Data Availability Statement
Acknowledgments
Conflicts of Interest
References
- Turnbull, C.; Lillemo, M.; Hvoslef-Eide, T.A.K. Global Regulation of Genetically Modified Crops Amid the Gene Edited Crop Boom—A Review. Front. Plant Sci. 2021, 12, 258. [Google Scholar] [CrossRef] [PubMed]
- Zhao, Y.; Lloyd, J.R.; Kossmann, J. Improving Crops for a Changing World. Front. Plant Sci. 2021, 1, 728328. [Google Scholar] [CrossRef]
- Bortesi, L.; Fischer, R. The CRISPR/Cas9 system for plant genome editing and beyond. Biotechnol. Adv. 2015, 33, 41–52. [Google Scholar] [CrossRef] [PubMed]
- Fauser, F.; Schiml, S.; Puchta, H. Both CRISPR/Cas-based nucleases and nickases can be used efficiently for genome engineering in Arabidopsis thaliana. Plant J. 2014, 79, 348–359. [Google Scholar] [CrossRef] [PubMed]
- Gao, C. Leading Edge Genome engineering for crop improvement and future agriculture. Cell 2021, 184, 1621–1635. [Google Scholar] [CrossRef]
- Jaganathan, D.; Ramasamy, K.; Sellamuthu, G.; Jayabalan, S.; Venkataraman, G. CRISPR for crop improvement: An update review. Front. Plant Sci. 2018, 9, 985. [Google Scholar] [CrossRef]
- Nekrasov, V.; Staskawicz, B.; Weigel, D.; Jones, J.D.G.; Kamoun, S. Targeted mutagenesis in the model plant Nicotiana benthamiana using Cas9 RNA-guided endonuclease. Nat. Biotechnol. 2013, 31, 691–693. [Google Scholar] [CrossRef]
- Shan, Q.; Wang, Y.; Li, J.; Zhang, Y.; Chen, K.; Liang, Z.; Zhang, K.; Liu, J.; Xi, J.J.; Qiu, J.-L.; et al. Targeted genome modification of crop plants using a CRISPR-Cas system. Nat. Biotechnol. 2013, 31, 686–688. [Google Scholar] [CrossRef]
- Li, J.-F.; Norville, J.E.; Aach, J.; McCormack, M.; Zhang, D.; Bush, J.; Church, G.M.; Sheen, J. Multiplex and homologous recombination–mediated genome editing in Arabidopsis and Nicotiana benthamiana using guide RNA and Cas9. Nat. Biotechnol. 2013, 31, 688–691. [Google Scholar] [CrossRef]
- Woo, J.W.; Kim, J.; Kwon, S.I.; Corvalán, C.; Cho, S.W.; Kim, H.; Kim, J.S. DNA-free genome editing in plants with preassembled CRISPR-Cas9 ribonucleoproteins. Nat. Biotechnol. 2015, 33, 1162–1164. [Google Scholar] [CrossRef]
- Endo, M.; Toki, S. Creation of herbicide-tolerant crops by gene targeting. J. Pestic. Sci. 2013, 38, 49–59. [Google Scholar] [CrossRef]
- Tian, S.; Jiang, L.; Cui, X.; Zhang, J.; Guo, S.; Li, M.; Zhang, H.; Ren, Y.; Gong, G.; Zong, M.; et al. Engineering herbicide-resistant watermelon variety through CRISPR/Cas9-mediated base-editing. Plant Cell Rep. 2018, 37, 1353–1356. [Google Scholar] [CrossRef] [PubMed]
- Sun, Y.; Zhang, X.; Wu, C.; He, Y.; Ma, Y.; Hou, H.; Guo, X.; Du, W.; Zhao, Y.; Xia, L. Engineering Herbicide-Resistant Rice Plants through CRISPR/Cas9-Mediated Homologous Recombination of Acetolactate Synthase. Mol. Plant 2016, 9, 628–631. [Google Scholar] [CrossRef] [PubMed]
- Li, Y.; Zhu, J.; Wu, H.; Liu, C.; Huang, C.; Lan, J.; Zhao, Y.; Xie, C. Precise base editing of non-allelic acetolactate synthase genes confers sulfonylurea herbicide resistance in maize. Crop J. 2020, 8, 449–456. [Google Scholar] [CrossRef]
- Aufsatz, W.; Nehlin, L.; Voronin, V.; Schmidt, A.; Matzke, A.J.M.; Matzke, M. A novel strategy for obtaining kanamycin resistance in Arabidopsis thaliana by silencing an endogenous gene encoding a putative chloroplast transporter. Biotechnol. J. 2009, 4, 224–229. [Google Scholar] [CrossRef] [PubMed]
- Conte, S.; Stevenson, D.; Furner, I.; Lloyd, A. Multiple Antibiotic Resistance in Arabidopsis Is Conferred by Mutations in a Chloroplast-Localized Transport Protein. Plant Physiol. 2009, 151, 559–573. [Google Scholar] [CrossRef] [PubMed]
- Rinne, J.; Witte, C.-P.; Herde, M. Loss of MAR1 Function is a Marker for Co-Selection of CRISPR-Induced Mutations in Plants. Front. Genome Ed. 2021, 3, 723384. [Google Scholar] [CrossRef]
- Kim, L.J.; Tsuyuki, K.M.; Hu, F.; Park, E.Y.; Zhang, J.; Iraheta, J.G.; Chia, J.C.; Huang, R.; Tucker, A.E.; Clyne, M.; et al. Ferroportin 3 is a dual-targeted mitochondrial/chloroplast iron exporter necessary for iron homeostasis in Arabidopsis. Plant J. 2021, 107, 215–236. [Google Scholar] [CrossRef]
- Van Bambeke, F.; Balzi, E.; Tulkens, P. Antibiotic efflux pumps. Biochem. Pharmacol. 2000, 60, 457–470. [Google Scholar] [CrossRef]
- Conte, S.; Lloyd, A. The MAR1 transporter is an opportunistic entry point for antibiotics. Plant Signal. Behav. 2010, 5, 49–52. [Google Scholar] [CrossRef]
- Kashiwagi, K.; Miyaji, A.; Ikeda, S.; Tobe, T.; Sasakawa, C.; Igarashi, K. Increase of sensitivity to aminoglycoside antibiotics by polyamine-induced protein (oligopeptide-binding protein) in Escherichia coli. J. Bacteriol. 1992, 174, 4331–4337. [Google Scholar] [CrossRef][Green Version]
- Nicotiana Tabacum Genome Data. Available online: https://solgenomics.net/organism/Nicotiana_tabacum/genome (accessed on 16 March 2020).
- Kumar, S.; Stecher, G.; Tamura, K. MEGA7: Molecular Evolutionary Genetics Analysis Version 7.0 for Bigger Datasets. Mol. Biol. Evol. 2016, 33, 1870–1874. [Google Scholar] [CrossRef] [PubMed]
- CCTop—CRISPR/Cas9 Target Online Predictor. Available online: https://cctop.cos.uni-heidelberg.de:8043/index.html (accessed on 16 March 2020).
- Kaya, H.; Mikami, M.; Endo, A.; Endo, M.; Toki, S. Highly specific targeted mutagenesis in plants using Staphylococcus aureus Cas9. Sci. Rep. 2016, 6, 26871. [Google Scholar] [CrossRef] [PubMed]
- Kurokawa, S.; Rahman, H.; Yamanaka, N.; Ishizaki, C.; Islam, S.; Aiso, T.; Hirata, S.; Yamamoto, M.; Kobayashi, K.; Kaya, H. A Simple Heat Treatment Increases SpCas9-Mediated Mutation Efficiency in Arabidopsis. Plant Cell Physiol. 2021, 62, 1676–1686. [Google Scholar] [CrossRef] [PubMed]
- Svab, Z.; Hajdukiewicz, P.; Maliga, P. Stable transformation of plastids in higher plants. Proc. Natl. Acad. Sci. USA 1990, 87, 8526–8530. [Google Scholar] [CrossRef] [PubMed]
- Edwards, K.; Johnstone, C.; Thompson, C. A simple and rapid method for the preparation of plant genomic DNA for PCR analysis. Nucleic Acids Res. 1991, 19, 1349. [Google Scholar] [CrossRef] [PubMed]
- Kasajima, I.; Ide, Y.; Ohkama-Ohtsu, N.; Hayashi, H.; Yoneyama, T.; Fujiwara, T. A protocol for rapid DNA extraction from Arabidopsis thaliana for PCR analysis. Plant Mol. Biol. Report. 2004, 22, 49–52. [Google Scholar] [CrossRef]
- CRISPResso 2. Available online: https://crispresso.pinellolab.partners.org/submission (accessed on 2 March 2021).

Publisher’s Note: MDPI stays neutral with regard to jurisdictional claims in published maps and institutional affiliations. |
© 2022 by the authors. Licensee MDPI, Basel, Switzerland. This article is an open access article distributed under the terms and conditions of the Creative Commons Attribution (CC BY) license (https://creativecommons.org/licenses/by/4.0/).
Share and Cite
Rahman, H.; Fukushima, C.; Kaya, H.; Yaeno, T.; Kobayashi, K. Knockout of Tobacco Homologs of Arabidopsis Multi-Antibiotic Resistance 1 Gene Confers a Limited Resistance to Aminoglycoside Antibiotics. Int. J. Mol. Sci. 2022, 23, 2006. https://doi.org/10.3390/ijms23042006
Rahman H, Fukushima C, Kaya H, Yaeno T, Kobayashi K. Knockout of Tobacco Homologs of Arabidopsis Multi-Antibiotic Resistance 1 Gene Confers a Limited Resistance to Aminoglycoside Antibiotics. International Journal of Molecular Sciences. 2022; 23(4):2006. https://doi.org/10.3390/ijms23042006
Chicago/Turabian StyleRahman, Hafizur, Chika Fukushima, Hidetaka Kaya, Takashi Yaeno, and Kappei Kobayashi. 2022. "Knockout of Tobacco Homologs of Arabidopsis Multi-Antibiotic Resistance 1 Gene Confers a Limited Resistance to Aminoglycoside Antibiotics" International Journal of Molecular Sciences 23, no. 4: 2006. https://doi.org/10.3390/ijms23042006
APA StyleRahman, H., Fukushima, C., Kaya, H., Yaeno, T., & Kobayashi, K. (2022). Knockout of Tobacco Homologs of Arabidopsis Multi-Antibiotic Resistance 1 Gene Confers a Limited Resistance to Aminoglycoside Antibiotics. International Journal of Molecular Sciences, 23(4), 2006. https://doi.org/10.3390/ijms23042006

